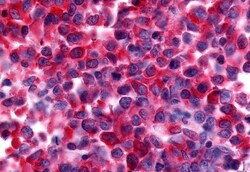
Invitrogen NEK9 Polyclonal Antibody 50 &mu;g; Unconjugated:Antibodies,

missing translation for 'onlineSavingsMsg'
Learn More
Learn More
Invitrogen™ NEK9 Polyclonal Antibody


Rabbit Polyclonal Antibody
Brand: Invitrogen™ PA533962
This item is not returnable.
View return policy
Description
Percent identity with other species by BLAST analysis: Human, Gorilla, Gibbon (100%) Monkey, Marmoset (89%).
NEK9, a NEK type protein kinase, regulates chromosome alignment and segregation in mitosis. The protein has a N-terminal NIMA-like catalytic domain, a central domain with homology to the guanine nucleotide exchange factor for the GTPase Ran (RCC1), and a C-terminal coiled-coil domain. It is phosphorylated by active p34(Cdc2) and is capable of autophosphorylation and oligomerization. The activated protein binds Nek6 and RCC1, and has been shown to associate with the human homolog of the Drosophila protein Bicaudal D (Bicd2) in vivo and to phosphorylate this coiled-coil protein in vitro. NEK9 expression has been documented in normal human brain. ESTs have been isolated from several tissue libraries, including normal bone, lymph and thymus and cancerous cervix, eye, lymph and placenta.
Specifications
| NEK9 | |
| Polyclonal | |
| Unconjugated | |
| NEK9 | |
| APUG; C130021H08Rik; DKFZp434D0935; KIAA1995; LCCS10; MGC138306; MGC16714; NC; NEK 9; NEK8; NEK9; Nercc; Nercc 1 kinase; NERCC1; Nercc1 kinase; never in mitosis A-related kinase 9; NIMA (never in mitosis gene a)- related kinase 9; NIMA (never in mitosis gene a)-related expressed kinase 9; NIMA related kinase 9; NimA-related kinase 8; NIMA-related kinase 9; nimA-related protein kinase 9; Serine/threonine-protein kinase Nek9 | |
| Rabbit | |
| Antigen affinity chromatography | |
| RUO | |
| 91754 | |
| Store at 4°C short term. For long term storage, store at -20°C, avoiding freeze/thaw cycles. | |
| Liquid |
| Immunohistochemistry (Paraffin) | |
| 1 mg/mL | |
| PBS with 0.1% sodium azide | |
| Q8TD19 | |
| NEK9 | |
| Synthetic 19 amino acid peptide from Pro/Ser/Thr rich domain of human NEK9. | |
| 50 μg | |
| Primary | |
| Human | |
| Antibody | |
| IgG |
Product Content Correction
Your input is important to us. Please complete this form to provide feedback related to the content on this product.
Product Title
Spot an opportunity for improvement?Share a Content Correction